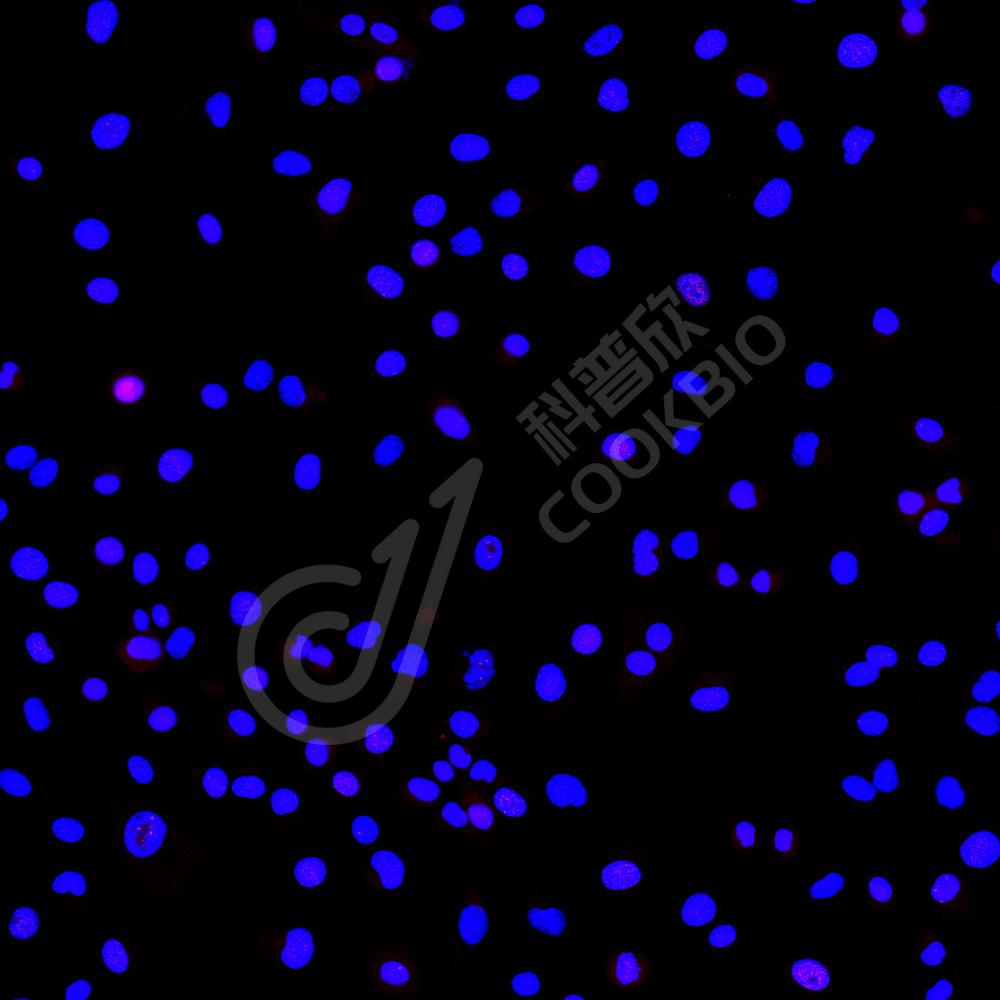

抗体筛选:
抗体筛选:
-
Anti-Phospho-H2A.X (S139) 兔多克隆抗体 兔多抗修饰抗体,组蛋白相关货号:K1335523-100 规格:100 μL ¥ 1900比较查看详情
-
Anti-Phospho-TAU (S202/T205) 兔多克隆抗体 兔多抗神经退行性疾病,修饰抗体货号:K1341649-100 规格:100 μL ¥ 1900比较查看详情
-
Anti-Phospho-EGF Receptor (Y1172) 兔多克隆抗体 兔多抗修饰抗体,生长因子及受体货号:K1342597-100 规格:100 μL ¥ 1900比较查看详情
-
Anti-Phospho-PTEN(S380) 兔多克隆抗体 兔多抗原癌/抑癌基因蛋白,修饰抗体货号:K1343749-100 规格:100 μL ¥ 1900比较查看详情
-
Anti-Phospho-S6 Ribosomal Protein (S235/S236) 兔多克隆抗体 兔多抗修饰抗体,核糖体亚基货号:K1346905-100 规格:100 μL ¥ 1900比较查看详情
-
Anti-Phospho-S6 Ribosomal Protein (S240/S244) 兔多克隆抗体 兔多抗修饰抗体,核糖体亚基货号:K1346908-100 规格:100 μL ¥ 1900比较查看详情
-
Anti-Phospho-EGFR(Y1069) 兔多克隆抗体 兔多抗修饰抗体,生长因子及受体货号:K1346986-100 规格:100 μL ¥ 1900比较查看详情
-
Recombinant Anti-Phospho-STAT3(Y705) antibody (兔单克隆抗体) 兔单抗 重组重组抗体,修饰抗体,转录因子货号:K5450003-100 规格:100 μL ¥ 1900比较查看详情
-
Recombinant Anti-Phospho-GSK3 Beta(S9) antibody (兔单克隆抗体) 兔单抗 重组重组抗体,修饰抗体,其它货号:K5450150-100 规格:100 μL ¥ 1900比较查看详情
-
Recombinant Anti-Phospho-Tau(S202/T205) antibody (兔单克隆抗体) 兔单抗 重组神经退行性疾病,重组抗体,修饰抗体货号:K5450180-100 规格:100 μL ¥ 1900比较查看详情
需要技术支持?
如果您有任何问题或如果您在实验过程中遇到问题,或需要更详细的技术指导,请联系我们的技术支持团队
 400-6027-270
400-6027-270
联系我们
如果您对我们的公司或产品有任何疑问,欢迎随时联系我们

湖北省武汉市东湖新技术开发区高新二路388号生物医药加速器22栋5楼
湖北省武汉市东湖新技术开发区高新二路388号生物医药加速器22栋5楼  400-6027-270
400-6027-270  鄂公网安备42018502008544号
鄂公网安备42018502008544号